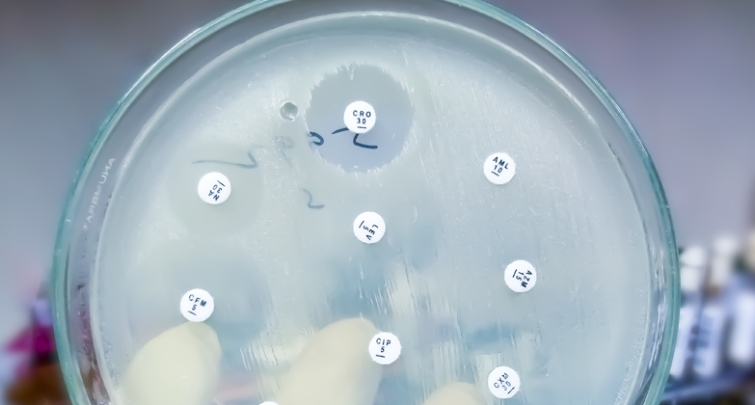
FORMATION -14 MARS. Tout savoir sur la lutte contre l’antibiorésistance et le rôle du biologiste médical !

ACTUALITÉ SYNDICALE (271)
24 février 2023
Le SDBIO organise le 14 mars après-midi (14-17 heures) en présentiel et distanciel une formation sur la prévention des infections et de l’antibiorésis ...

24 janvier 2023
Nul ne peut prédire le devenir des travaux de consultation réalisés dans le cadre du CNR Santé et du CNR Bien vieillir dont nous devrions avoir les co ...

19 janvier 2023
Les Dr François Blanchecotte, Président du SDBIO, Bruno Gauthier et Henry-Pierre Doermann, vice-Présidents du SDBIO, ont été auditionnés par la Cour d ...

10 janvier 2023
Les syndicats représentatifs de la profession ont signé cet après-midi (mardi 10 janvier) un accord avec la Cnam. Une décision prise en concertation a ...

06 janvier 2023
Les membres de l'Alliance de la biologie médicale (ABM) adressent une lettre ouverte au Président de la République pour lui demander de ne pas laisser ...

23 décembre 2022
François Blanchecotte, Président du SDBIO, et les membres du Bureau national du SDBIO vous souhaitent de très belles fêtes de fin d'année et vous donn ...

16 décembre 2022
Par courrier en date du 15 décembre 2022, le Dr François Blanchecotte a saisi Thomas Fatôme, Directeur général de la Caisse Nationale d’Assurance ...

15 décembre 2022
Devant la surdité des pouvoirs publics sur les risques qu’une économie de 1,3 milliards d’euros ferait peser sur les laboratoires de biologie médicale ...

02 décembre 2022
Au 2e jour de leur grève commune avec les autres professionnels de santé, les biologistes médicaux réitèrent leur appel au dialogue avec le gou ...

24 novembre 2022
Ce mardi, au nom de l’ABM, les syndicats de biologie médicale ont réitéré, par courrier, leur proposition de participer à l’effort de guerre pour la ...

24 novembre 2022
Les journées de l’innovation en biologie se tiennent la semaine prochaine, les 1er et 2 décembre.
Conférences scientifiques de haut niveau, tabl ...

23 novembre 2022
Le lundi 21 novembre, le Directeur général de l’Assurance maladie a reçu les syndicats de la profession, acceptant de reprendre le dialogue sur les ...


![[BIO-M] SEMAINE DU REIN : Les biologistes mobilisés contre les maladies rénales](/media/k2/items/cache/e8b840056379c98e602db5d2011f7e39_L.jpg)

